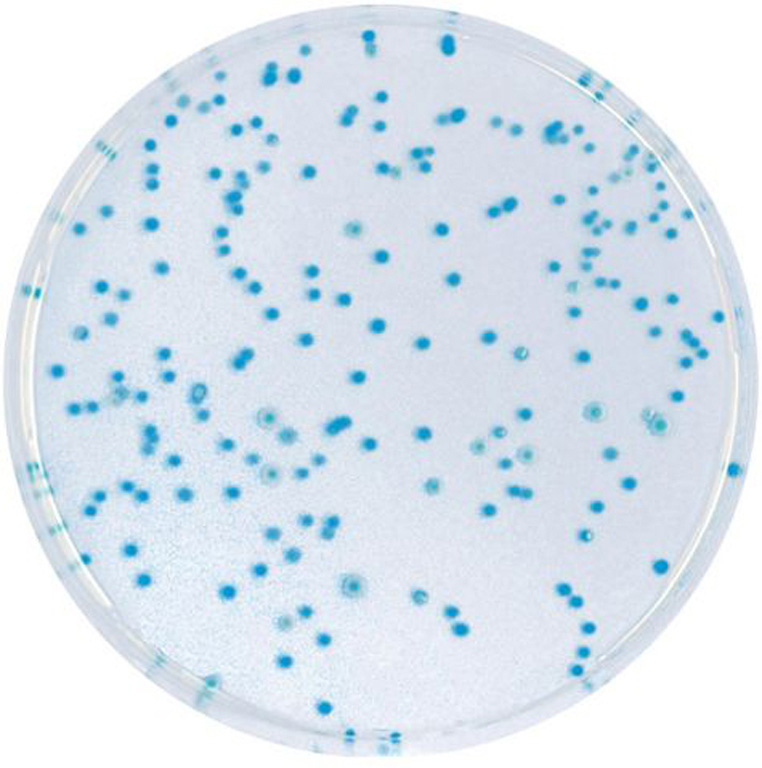

Über das Produkt
Chromogener Coliformen Agar zum Nachweis und zur Zählung von ß-Glukuronidase-positiven E. coli und Coliformen aus Wasserproben mit geringer Hintergrundflora (nach ISO 9308-1).
CHROMagar E.coli (5L) - ohne CE
Chromogener Coliformen Agar zum Nachweis und zur Zählung von ß-Glukuronidase-positiven E. coli und Coliformen aus Wasserproben mit geringer Hintergrundflora (nach ISO 9308-1).